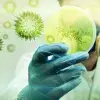

Ya que el nuevo coronavirus que provoca el COVID-19 se transmite por las secreciones que las personas proyectan por nariz y boca que se inhalan o que quedan en superficies.
Además, las personas producen una "nube" de partículas líquidas de pequeñas gotas microscópicas solo con respirar. Esa "nube" de una persona infectada tiene el potencial de contagiar a otras personas.
Esa nube y que las secreciones expulsadas por una persona infectada pueden llegar a superficies, que pueden tener contacto con los zapatos y la ropa de una persona.
Un estudio de The New England Journal of Medicine analiza cómo sobrevive el nuevo coronavirus en distintas superficies.
El SARS-CoV-2 es viable en aerosoles hasta por 3 horas; en acero inoxidable y plástico, hasta 3 días de sobrevida; en cobre, 4 horas; y en cartón hasta 24 horas.
Sin embargo, no se ha estudiado cuánto tiempo permanece activo el virus en ropa y zapatos.
AL LLEGAR A CASA
Quitarse de inmediato los zapatos justo al entrar a casa y rociarlos con algún producto desinfectante que debe estar a la entrada.
Se recomienda dejar ese calzado a la entrada en un recipiente y usar otro par para andar en el hogar.

LA ROPA
Al entrar a casa, se recomienda quitarse la ropa exterior y mételarla en una bolsa o recipiente para lavarla lo más pronto posible. Esto se aconseja principalmente para profesionales de la salud.
Luego de quitarse la ropa se recomienda darse un baño lo más pronto que se pueda. En caso de que no sea posible, se recomienda lavar todas las partes del cuerpo expuestas (manos, cuello, brazos, muñecas).
Para el lavado de ropa debe hacerse a temperatura de 60 a 90 grados y detergente, según la Organización Mundial de la Salud (OMS). Esto incluye sábanas y toallas.
La OMS indica que si no es posible usar una lavadora, se pueden dejar en remojo en agua caliente y jabón.

LAS MONEDAS, LAS LLAVES, EL BOLSO...
Al entrar a casa se recomienda dejar los artículos que traigamos con nosotros como: mochila, monedas, llaves, bolso, cartera, entre otros, en un recipiente o bolsa para rociarlos con algún producto desinfectante.
Después proceder al lavado de manos con agua y jabón por un tiempo mínimo de 40 a 60 segundos, o usar gel antibacterial a base de alcohol al 70%.
¿CÓMO SE DEBE LIMPIAR LA CASA?
El Centro para el Control y la Prevención de Enfermedades (CDC) de Estados Unidos recomienda limpiar “todos los días todas las superficies de contacto frecuente”.
Estos pueden ser "mesas, las manijas de las puertas, los interruptores de luz, los mesones, las barandas, los escritorios, los teléfonos, los teclados, los inodoros, los grifos, los lavamanos y los lavaplatos".
De acuerdo con la CDC, la mayoría de los desinfectantes comunes para el hogar pueden servir. Recomienda usar los desinfectantes adecuados para el tipo de superficie.

LOS DESINFECTANTES
Las opciones de desinfectantes pueden ser:
* Diluir el blanqueador con cloro que tenga en casa.
Se recomienda usar una proporción cloro/agua de 1:3
* Soluciones de alcohol.
Asegúrate de que la solución tenga al menos un 70% de alcohol.
* Otros desinfectantes comunes para el hogar
Siga las instrucciones del fabricante para todos los productos de limpieza y desinfección (como la concentración, método de aplicación y tiempo de contacto, etc.).
Puedes consultar más productos desinfectantes comerciales aquí.
“Cada uno de nosotros somos responsables de nuestra salud, por lo que los exhorto a seguir las medidas básicas prevención para evitar la rápida propagación de COVID-19”, dice el Dr. Michel Fernando Martínez, líder de la Unidad de Vigilancia Epidemiológica de TecSalud.
ESTE ES EL SITIO DONDE SE IRÁ ACTUALIZANDO INFORMACIÓN:
Y EL ESPECIAL DE CONECTA CON NOTAS SOBRE EL CORONAVIRUS: